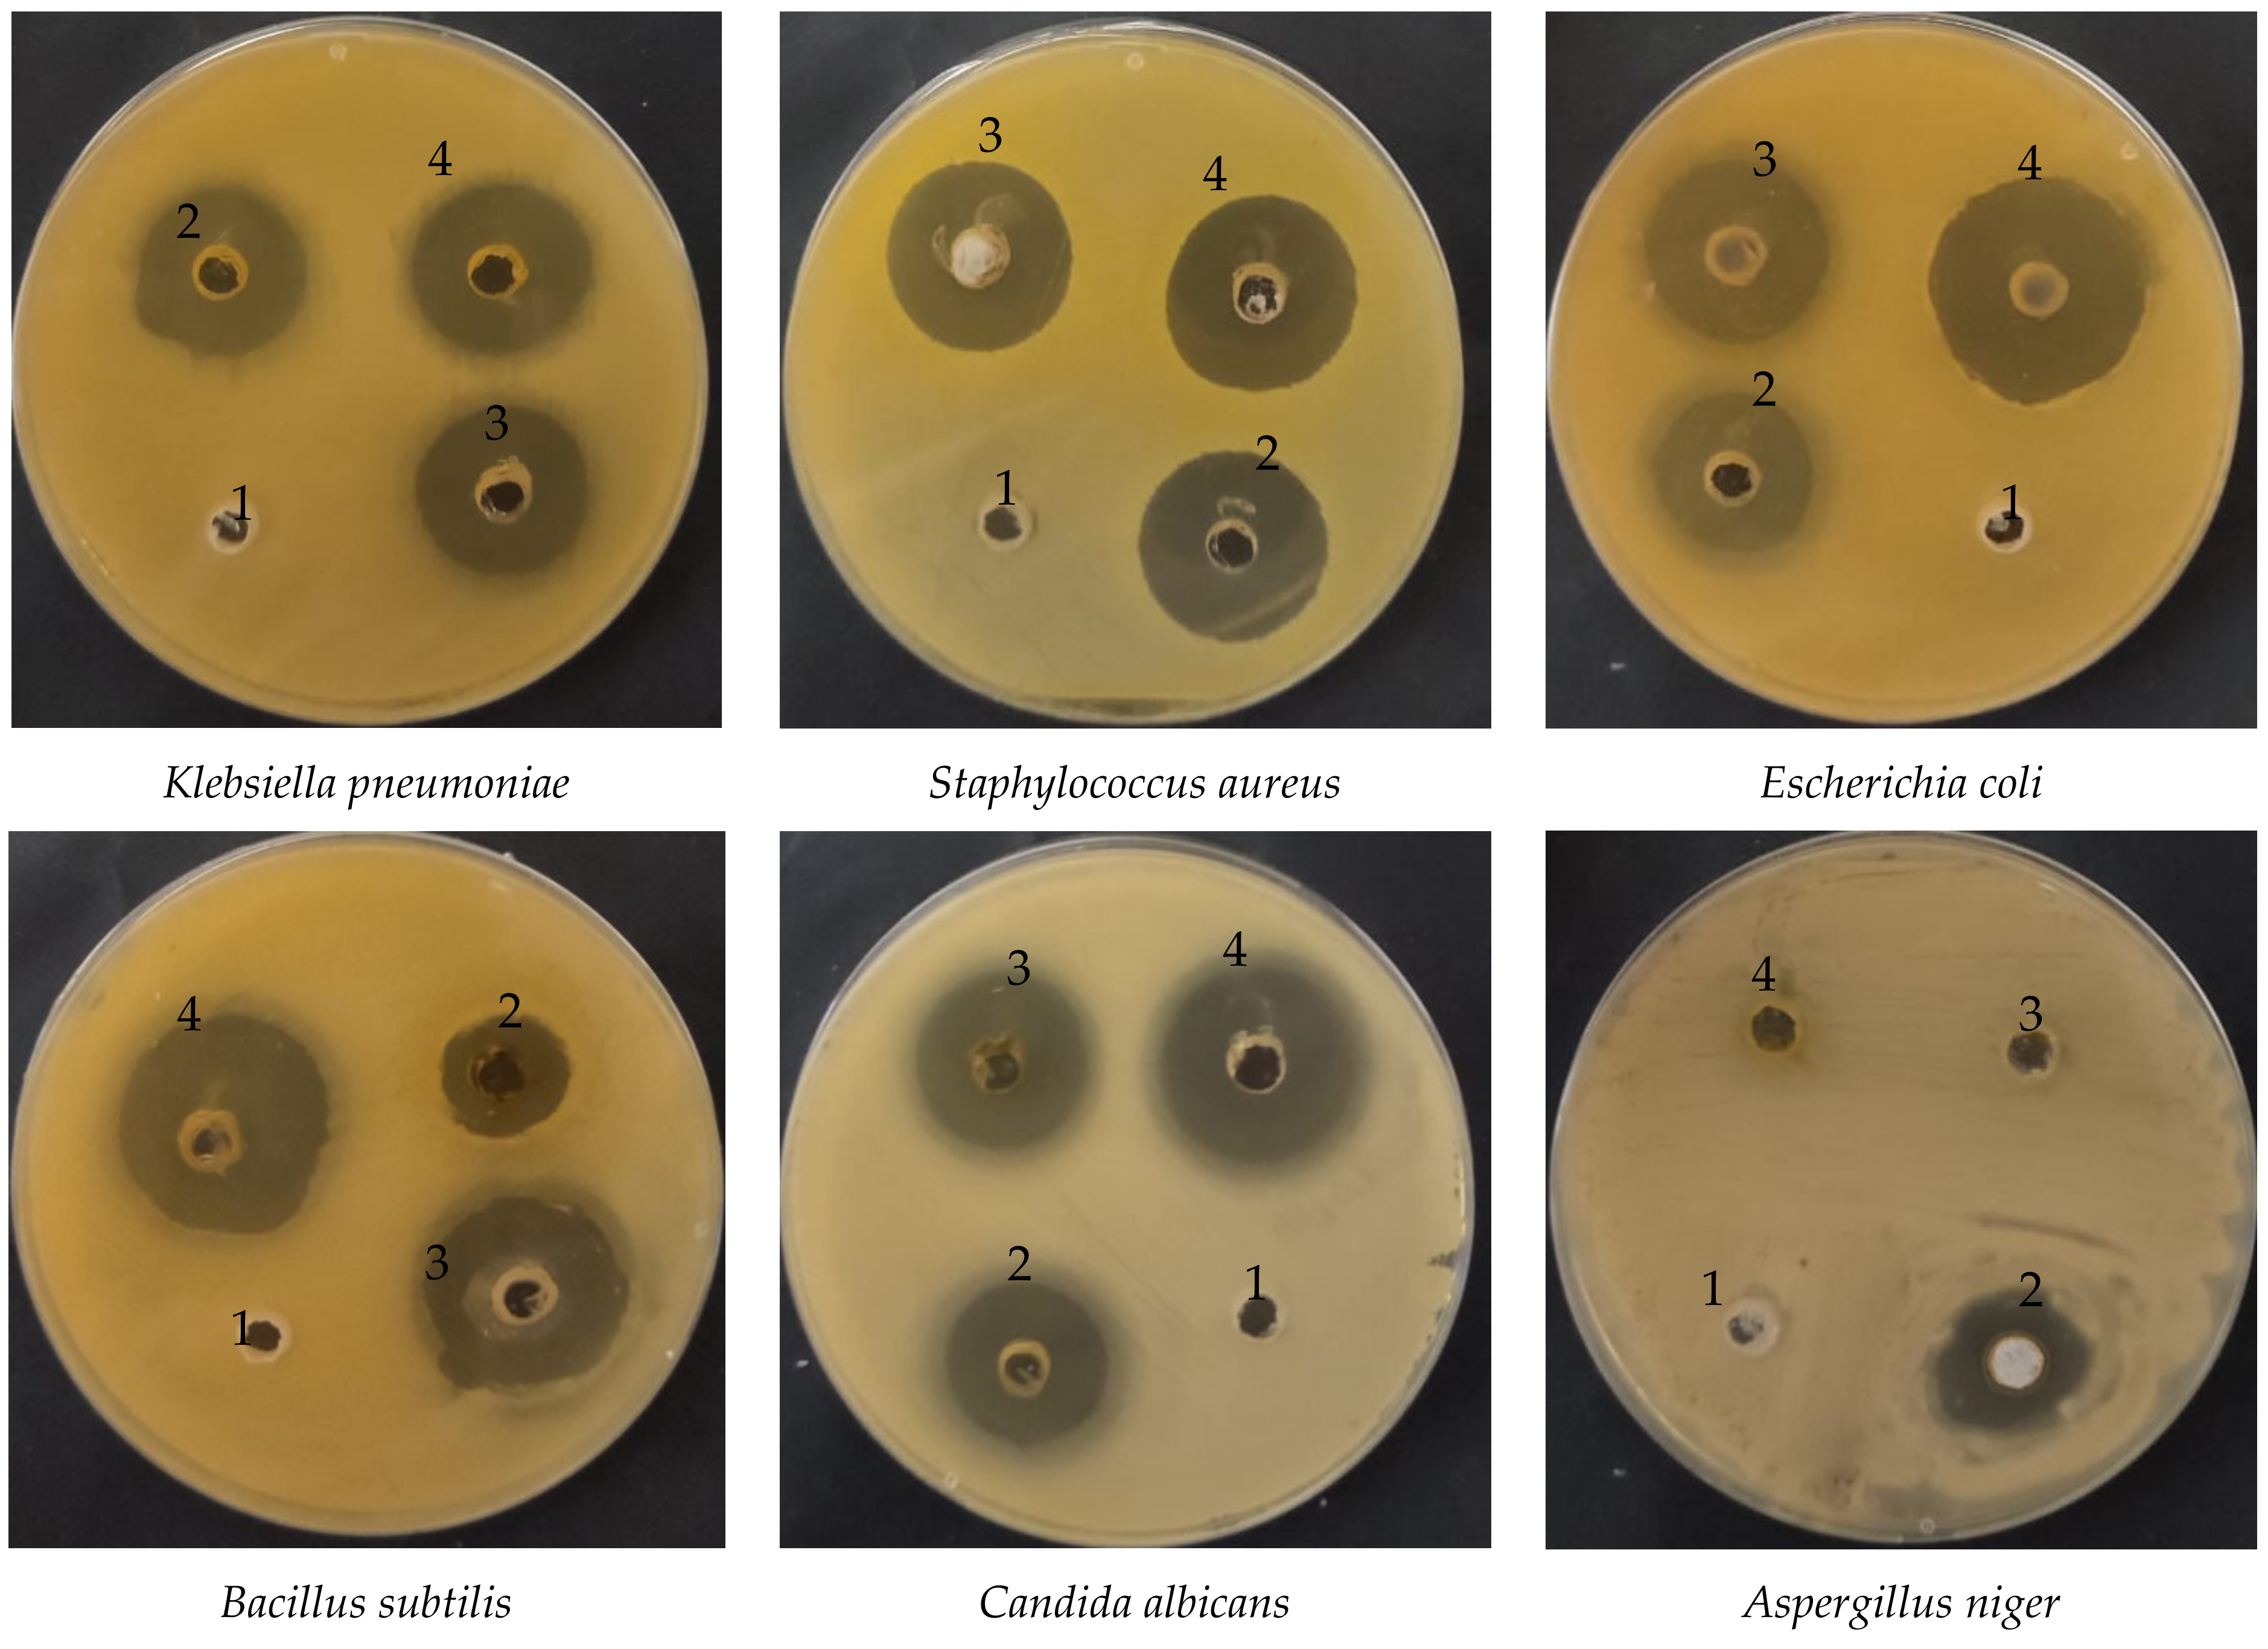

Phytochemical Characterization and Efficacy of Artemisia judaica Extract Loaded Chitosan Nanoparticles as Inhibitors of Cancer Proliferation and Microbial Growth
Abstract
1. Introduction
2. Materials and Methods
2.1. Source of Chitosan Nanoparticles
2.2. Plant Collection and Extraction
2.3. Loading of A. judaica into Chitosan Nanoparticles
2.4. HPLC Analysis
2.5. Agar Well Diffusion Assay
2.6. Minimal Inhibitory Concentration (MIC)
2.7. Cell Viability Assay
2.8. Molecular Docking
2.9. Statistical Analysis
3. Results and Discussion
3.1. Phenolic and Flavonoid Analysis
3.2. Antimicrobial Activity
3.3. Anticancer Activity
3.4. Molecular Docking of Kaempferol and Apigenin with Prostate Cancer (2Q7L)
4. Conclusions
Author Contributions
Funding
Institutional Review Board Statement
Data Availability Statement
Acknowledgments
Conflicts of Interest
References
- Abdelghany, T.; Yahya, R.; Bakri, M.M.; Ganash, M.; Amin, B.H.; Qanash, H. Effect of Thevetia peruviana seeds extract for microbial pathogens and cancer control. Int. J. Pharmacol. 2021, 17, 643–655. [Google Scholar] [CrossRef]
- Al-Rajhi, A.M.H.; Yahya, R.; Bakri, M.M.; Yahya, R.; Abdelghany, T.M. In situ green synthesis of Cu-doped ZnO based polymers nanocomposite with studying antimicrobial, antioxidant and anti-inflammatory activities. Appl. Biol. Chem. 2022, 65, 35. [Google Scholar] [CrossRef]
- Qanash, H.; Yahya, R.; Bakri, M.M.; Bazaid, A.S.; Qanash, S.; Shater, A.F.; Abdelghany, T.M. Anticancer, antioxidant, antiviral and antimicrobial activities of Kei Apple (Dovyalis caffra) fruit. Sci. Rep. 2022, 12, 5914. [Google Scholar] [CrossRef]
- Mamatova, A.S.; Korona-Glowniak, I.; Skalicka-Woźniak, K.; Józefczyk, A.; Wojtanowski, K.K.; Baj, T.; Sakipova, Z.B.; Malm, A. Phytochemical composition of wormwood (Artemisia gmelinii) extracts in respect of their antimicrobial activity. BMC Complement. Altern. Med. 2019, 19, 288. [Google Scholar] [CrossRef] [PubMed]
- Bisht, D.; Kumar, D.; Kumar, D.; Dua, K.; Chellappan, D.K. Phytochemistry and pharmacological activity of the genus artemisia. Arch. Pharmacal Res. 2021, 44, 439–474. [Google Scholar] [CrossRef] [PubMed]
- El-Amier, Y.A.; Al Borki, A.E.-N.S.; Elagami, S.A. Potential of wild plant Artemisia judaica L. as sustainable source of antioxidant and antimicrobial compounds. J. Exp. Sci. 2019, 10, 4–8. [Google Scholar] [CrossRef]
- Bora, K.S.; Sharma, A. The Genus Artemisia: A Comprehensive Review. Pharm. Biol. 2011, 49, 101–109. [Google Scholar] [CrossRef]
- Mohammed, H.A.; Qureshi, K.A.; Ali, H.M.; Al-Omar, M.S.; Khan, O.; Mohammed, S.A.A. Bio-Evaluation of the Wound Healing Activity of Artemisia judaica L. as Part of the Plant’s Use in Traditional Medicine; Phytochemical, Antioxidant, Anti-Inflammatory, and Antibiofilm Properties of the Plant’s Essential Oils. Antioxidants 2022, 11, 332. [Google Scholar] [CrossRef]
- Abu-Darwish, M.S.; Cabral, C.; Gonçalves, M.J.; Cavaleiro, C.; Cruz, M.T.; Zulfiqar, A.; Khan, I.A.; Efferth, T.; Salgueiro, L. Chemical composition and biological activities of Artemisia judaica essential oil from southern desert of Jordan. J. Ethnopharmacol. 2016, 191, 161–168. [Google Scholar] [CrossRef]
- Nofal, S.; Mahmoud, S.; Ramadan, A.; Soliman, G.; Abdel-Rahman, R. Anti-Diabetic Effect of Artemisia judaica Extracts. Res. J. Med. Med. Sci. 2009, 4, 42–48. [Google Scholar]
- Bakr, R.O. Microscopical and Phytochemical Investigation of Egyptian Artemisia judaica L. Var. Sinaitica tackholm and its Free Radical Scavenging Activity. Int. J. Pharmacogn. Phytochem. Res. 2014, 6, 698–703. [Google Scholar]
- Abdelghany, T.M.; Al-Rajhi, A.M.H.; Al Abboud, M.A.; Alawlaqi, M.M.; Ganash Magdah, A.; Helmy, E.A.M.; Mabrouk, A.S. Recent Advances in Green Synthesis of Silver Nanoparticles and Their Applications: About Future Directions. A Review. BioNanoScience 2018, 8, 5–16. [Google Scholar] [CrossRef]
- Keawchaoon, L.; Yoksan, R. Preparation, characterization and in vitro release study of carvacrol-loaded chitosan nanoparticles. Colloids Surf. B Biointerfaces 2011, 84, 163–171. [Google Scholar] [CrossRef]
- Da Silva, S.B.; Amorim, M.; Fonte, P.; Madureira, R.; Ferreira, D.; Pintado, M.; Sarmento, B. Natural extracts into chitosan nanocarriers for rosmarinic acid drug delivery. Pharm. Biol. 2015, 53, 642–652. [Google Scholar] [CrossRef] [PubMed]
- Devi, C.S.; Tarafder, A. EteeShishodiya, and Mohanasrinivasan. Encapsulation of staphylokinase and Leucasaspera plant extracts using chitosan nanoparticles. Int. J. PharmTech Res. 2015, 7, 654–661. [Google Scholar]
- Manne, A.A.; Vinay Viswanath, K.; Ajay Kumar, G.; Mangamuri, U.; Podha, S. Pterocarpus marsupium Roxb. heartwood extract synthesized chitosan nanoparticles and its biomedical applications. J. Genet. Eng. Biotechnol. 2020, 18, 19. [Google Scholar] [CrossRef]
- Yahya, R.; Al-Rajhi, A.M.H.; Alzaid, S.Z.; Al Abboud, M.A.; Almuhayawi, M.S.; Al Jaouni, S.K.; Selim, S.; Ismail, K.S.; Abdelghany, T.M. Molecular Docking and Efficacy of Aloe vera Gel Based on Chitosan Nanoparticles against Helicobacter pylori and Its Antioxidant and Anti-Inflammatory Activities. Polymers 2022, 14, 2994. [Google Scholar] [CrossRef]
- Antunes, J.C.; Domingues, J.M.; Miranda, C.S.; Silva, A.F.G.; Homem, N.C.; Amorim, M.T.P.; Felgueiras, H.P. Bioactivity of Chitosan-Based Particles Loaded with Plant-Derived Extracts for Biomedical Applications: Emphasis on Antimicrobial Fiber-Based Systems. Mar. Drugs 2021, 19, 359. [Google Scholar] [CrossRef]
- Barrera-Necha, L.; Correa-Pacheco, Z.; Bautista-Baños, S.; Hernández-López, M.; Jiménez, J.; Mejía, A. Synthesis and Characterization of Chitosan Nanoparticles Loaded Botanical Extracts with Antifungal Activity on Colletotrichum gloeosporioides and Alternaria species. Adv. Microbiol. 2018, 8, 286–296. [Google Scholar] [CrossRef]
- Tran, T.H.; Nguyen, T.D.; Poudel, B.K.; Nguyen, H.T.; Kim, J.O.; Yong, C.S.; Nguyen, C.N. Development and Evaluation of Artesunate-Loaded Chitosan-Coated Lipid Nanocapsule as a Potential Drug Delivery System Against Breast Cancer. AAPS PharmSciTech 2015, 16, 1307–1316. [Google Scholar] [CrossRef]
- Haghighi, S.M.; Tafvizi, F.; Mirzaie, A. Encapsulation of Artemisia scoparia extract in chitosan-myristate nanogel with enhanced cytotoxicity and apoptosis against hepatocellular carcinoma cell line (Huh-7). Ind. Crop. Prod. 2020, 155, 112790. [Google Scholar] [CrossRef]
- Alipanah, H.; Yarian, F.; Rasti, F.; Safari, M.; Hatami, S.; Osanloo, M. Cytotoxic effects of chitosan nanoparticles containing Zataria multiflora essential oil against human breast and melanoma cells. Beni-Suef Univ. J. Basic Appl. Sci. 2022, 11, 58. [Google Scholar] [CrossRef]
- Abdelghany, T. Stachybotrys chartarum: A Novel Biological Agent for The Extracellular Synthesis of Silver Nanoparticles and Their Antimicrobial Activity. Indones. J. Biotechnol. 2013, 18, 75. [Google Scholar] [CrossRef]
- Abdelghany, T.M.; Al-Rajhi, A.M.H.; Yahya, R.; Bakri, M.M.; Al Abboud, M.A.; Yahya, R.; Qanash, H.; Bazaid, A.S.; Salem, S.S. Phytofabrication of zinc oxide nanoparticles with advanced characterization and its antioxidant, anticancer, and antimicrobial activity against pathogenic microorganisms. Biomass Convers. Biorefinery 2022, 13, 417–430. [Google Scholar] [CrossRef]
- Bazaid, A.S.; Alamri, A.; Almashjary, M.N.; Qanash, H.; Almishaal, A.A.; Amin, J.; Binsaleh, N.K.; Kraiem, J.; Aldarhami, A.; Alafnan, A. Antioxidant, Anticancer, Antibacterial, Antibiofilm Properties and Gas Chromatography and Mass Spectrometry Analysis of Manuka Honey: A Nature’s Bioactive Honey. Appl. Sci. 2022, 12, 9928. [Google Scholar] [CrossRef]
- Elasbali, A.M.; Al-Soud, W.A.; Al-Oanzi, Z.H.; Qanash, H.; Alharbi, B.; Binsaleh, N.K.; Alreshidi, M.; Patel, M.; Adnan, M. Cytotoxic Activity, Cell Cycle Inhibition, and Apoptosis-Inducing Potential of Athyrium hohenackerianum (Lady Fern) with Its Phytochemical Profiling. Evid.-Based Complement. Altern. Med. 2022, 2022, 2055773. [Google Scholar] [CrossRef] [PubMed]
- Kitchen, D.B.; Decornez, H.; Furr, J.R.; Bajorath, J. Docking and scoring in virtual screening for drug discovery: Methods and applications. Nat. Rev. Drug Discov. 2004, 3, 935–949. [Google Scholar] [CrossRef]
- Moharram, F.A.; Nagy, M.M.; El Dib, R.A.; el-Tantawy, M.M.; El Hossary, G.G.; El-Hosari, D.G. Pharmacological activity and flavonoids constituents of Artemisia judaica L. aerial parts. J. Ethnopharmacol. 2021, 270, 113777. [Google Scholar] [CrossRef]
- Allam, H.; Benamar, H.; Ben Mansour, R.; Ksouri, R.; Bennaceur, M. Phenolic Composition, Antioxidant, and Antibacterial Activities of Artemisia judaica Subsp. Sahariensis. J. Herbs Spices Med. Plants 2019, 25, 347–362. [Google Scholar] [CrossRef]
- Ren, J.; Lu, Y.; Qian, Y.; Chen, B.; Wu, T.; Ji, G. Recent progress regarding kaempferol for the treatment of various diseases (Review). Exp. Ther. Med. 2019, 18, 2759–2776. [Google Scholar] [CrossRef]
- Zhou, H.; Xu, M.; Guo, W.; Yao, Z.; Du, X.; Chen, L.; Sun, Y.; Shi, S.; Cao, J.; Zhou, T. The Antibacterial Activity of Kaempferol Combined with Colistin against Colistin-Resistant Gram-Negative Bacteria. Microbiol. Spectr. 2022, 10, e0226522. [Google Scholar] [CrossRef] [PubMed]
- Song, L.; Hu, X.; Ren, X.; Liu, J.; Liu, X. Antibacterial Modes of Herbal Flavonoids Combat Resistant Bacteria. Front. Pharmacol. 2022, 13, 873374. [Google Scholar] [CrossRef] [PubMed]
- Imam, S.S.; Alshehri, S.; Altamimi, M.A.; Almalki, R.K.H.; Hussain, A.; Bukhari, S.I.; Mahdi, W.A.; Qamar, W. Formulation of Chitosan-Coated Apigenin Bilosomes: In Vitro Characterization, Antimicrobial and Cytotoxicity Assessment. Polymers 2022, 14, 921. [Google Scholar] [CrossRef]
- Chen, K.; Peng, C.; Chi, F.; Yu, C.; Yang, Q.; Li, Z. Antibacterial and Antibiofilm Activities of Chlorogenic Acid against Yersinia enterocolitica. Front. Microbiol. 2022, 13, 885092. [Google Scholar] [CrossRef] [PubMed]
- Salehi, B.; Machin, L.; Monzote, L.; Sharifi-Rad, J.; Ezzat, S.M.; Salem, M.A.; Merghany, R.M.; El Mahdy, N.M.; Kılıç, C.S.; Sytar, O.; et al. Therapeutic Potential of Quercetin: New Insights and Perspectives for Human Health. ACS Omega 2020, 5, 11849–11872. [Google Scholar] [CrossRef]
- Asgharian, P.; Tazekand, A.P.; Hosseini, K.; Forouhandeh, H.; Ghasemnejad, T.; Ranjbar, M.; Hasan, M.; Kumar, M.; Beirami, S.M.; Tarhriz, V.; et al. Potential mechanisms of quercetin in cancer prevention: Focus on cellular and molecular targets. Cancer Cell Int. 2022, 22, 257. [Google Scholar] [CrossRef]
- Stabrauskiene, J.; Kopustinskiene, D.M.; Lazauskas, R.; Bernatoniene, J. Naringin and Naringenin: Their Mechanisms of Action and the Potential Anticancer Activities. Biomedicines 2022, 10, 1686. [Google Scholar] [CrossRef]
- Chen, S.-C.; Yang, C.-S.; Chen, J.-J. Main Bioactive Components and Their Biological Activities from Natural and Processed Rhizomes of Polygonum sibiricum. Antioxidants 2022, 11, 1383. [Google Scholar] [CrossRef]
- Sharifi-Rad, J.; Quispe, C.; Butnariu, M.; Rotariu, L.S.; Sytar, O.; Sestito, S.; Rapposelli, S.; Akram, M.; Iqbal, M.; Krishna, A.; et al. Chitosan nanoparticles as a promising tool in nanomedicine with particular emphasis on oncological treatment. Cancer Cell Int. 2021, 21, 318. [Google Scholar] [CrossRef]
- El-Naggar, N.E.-A.; Saber, W.I.A.; Zweil, A.M.; Bashir, S.I. An innovative green synthesis approach of chitosan nanoparticles and their inhibitory activity against phytopathogenic Botrytis cinerea on strawberry leaves. Sci. Rep. 2022, 12, 3515. [Google Scholar] [CrossRef]
- Al-Wahaibi, L.H.N.; Mahmood, A.; Khan, M.; Alkhathlan, H.Z. Comparative study on the essential oils of Artemisia judaica and A. herba-alba from Saudi Arabia. Arab. J. Chem. 2020, 13, 2053–2065. [Google Scholar] [CrossRef]
- Mohamed, T.A.; Hegazy, M.F.; Abd El Aty, A.A.; Ghabbour, H.A.; Alsaid, M.S.; Shahat, A.A.; Paré, P.W. Antimicrobial sesquiterpene lactones from Artemisia sieberi. J. Asian Nat. Prod. Res. 2017, 19, 1093–1101. [Google Scholar] [CrossRef] [PubMed]
- El-Aziz, A.R.M.A.; Al-Othman, M.R.; Mahmoud, M.; Shehata, S.; Abdelazim, N. Chitosan Nanoparticles as a Carrier for Mentha longifolia Extract:Synthesis, Characterization and Antifungal Activity. Curr. Sci. 2018, 114, 2116–2122. [Google Scholar] [CrossRef]
- Chouhan, S.; Sharma, K.; Guleria, S. Antimicrobial Activity of Some Essential Oils-Present Status and Future Perspectives. Medicines 2017, 4, 58. [Google Scholar] [CrossRef]
- Kain, D.; Kumar, S. Synthesis and characterization of chitosan nanoparticles of Achillea millefolium L. and their activities. F1000Research 2020, 9, 1297. [Google Scholar] [CrossRef]
- Qi, L.; Xu, Z.; Jiang, X.; Hu, C.; Zou, X. Preparation and antibacterial activity of chitosan nanoparticles. Carbohydr. Res. 2004, 339, 2693–2700. [Google Scholar] [CrossRef]
- Sharma, D.; Rajput, J.; Kaith, B.S.; Kaur, M.; Sharma, S. Synthesis of ZnO nanoparticles and study of their antibacterial and antifungal properties. Thin Solid Film. 2010, 519, 1224–1229. [Google Scholar] [CrossRef]
- Bagheri Farahani, Z.; Mirzaie, A.; Ashrafi, F.; Rahimpour Hesari, M.; Chitgar, A.; Noorbazargan, H.; Rahimi, A. Phytochemical composition and biological activities of Artemisia quettensis Podlech ethanolic extract. Nat. Prod. Res. 2017, 31, 2554–2558. [Google Scholar] [CrossRef]
- Alipour, M.; Reza Bigdeli, M.; Aligholi, H.; Rasoulian, B.; Khaksarian, M. Sustained release of silibinin-loaded chitosan nanoparticle induced apoptosis in glioma cells. J. Biomed. Mater. Res. A 2020, 108, 458–469. [Google Scholar] [CrossRef]
- Sujima-Anbu, A.; Sahi, S.; Perumal, V. Synthesis of Bioactive Chemicals Cross-linked Sodium Tripolyphosphate (TPP)-Chitosan Nanoparticles for Enhanced Cytotoxic Activity against Human Ovarian Cancer cell Line (PA-1). J. Nanomed. Nanotechnol. 2016, 7, 1–9. [Google Scholar] [CrossRef]
- Al-Rajhi, A.M.H.; Yahya, R.; Abdelghany, T.M.; Fareid, M.A.; Mohamed, A.M.; Amin, B.H.; Masrahi, A.S. Anticancer, Anticoagulant, Antioxidant and Antimicrobial Activities of Thevetia peruviana Latex with Molecular Docking of Antimicrobial and Anticancer Activities. Molecules 2022, 27, 3165. [Google Scholar] [CrossRef] [PubMed]
- Al-Rajhi, A.M.H.; Qanash, H.; Almuhayawi, M.S.; Al Jaouni, S.K.; Bakri, M.M.; Ganash, M.; Salama, H.M.; Selim, S.; Abdelghany, T.M. Molecular Interaction Studies and Phytochemical Characterization of Mentha pulegium L. Constituents with Multiple Biological Utilities as Antioxidant, Antimicrobial, Anticancer and Anti-Hemolytic Agents. Molecules 2022, 27, 4824. [Google Scholar] [CrossRef] [PubMed]
- Al-Rajhi, A.M.H.; Mashraqi, A.; Al Abboud, M.A.; Shater, A.-R.M.; Al Jaouni, S.K.; Selim, S.; Abdelghany, T.M. Screening of Bioactive Compounds from Endophytic Marine-Derived Fungi in Saudi Arabia: Antimicrobial and Anticancer Potential. Life 2022, 12, 1182. [Google Scholar] [CrossRef] [PubMed]

| Compound | Retention Time | Area | Area (%) | Concentration (µg/mL) |
|---|---|---|---|---|
| Gallic acid | 3.46 | 75.38 | 1.41 | 225.96 |
| Chlorogenic acid | 4.21 | 191.54 | 3.60 | 1089.58 |
| Catechin | 4.79 | 16.97 | 0.32 | 167.62 |
| Methyl gallate | 5.66 | 12.29 | 0.23 | 27.68 |
| Caffeic acid | 6.06 | 44.82 | 0.84 | 134.14 |
| Syringic acid | 6.54 | 80.26 | 1.51 | 244.74 |
| Rutin | 8.25 | 11.77 | 0.22 | 55.64 |
| Ellagic acid | 8.44 | 12.86 | 0.24 | 134.23 |
| Coumaric acid | 9.25 | 5.31 | 0.10 | 5.46 |
| Vanillin | 9.58 | 569.10 | 10.68 | 691.55 |
| Ferulic acid | 10.28 | 66.65 | 1.25 | 139.74 |
| Naringenin | 10.53 | 53.46 | 1.00 | 202.14 |
| Daidzein | 12.34 | 28.78 | 0.54 | 69.63 |
| Quercetin | 12.85 | 147.66 | 2.77 | 714.97 |
| Cinnamic acid | 13.59 | 109.08 | 2.05 | 83.29 |
| Apigenin | 14.53 | 1629.47 | 30.58 | 3794.32 |
| Kaempferol | 15.01 | 652.66 | 12.25 | 3916.34 |
| Hesperetin | 15.61 | 11.53 | 0.22 | 25.09 |
| Unknown | 2.64 | 1057.93 | 19.86 | Undetected |
| Unknown | 3.00 | 104.30 | 1.96 | Undetected |
| Unknown | 10.06 | 327.02 | 6.14 | Undetected |
| Unknown | 12.64 | 119.03 | 2.23 | Undetected |
| Microorganisms | MIC µg/mL | |
|---|---|---|
| CNPsLE | Extract | |
| Bacillus subtilis | 0.97 | 62.5 |
| Staphylococcus aureus | 3.90 | 15.65 |
| Escherichia coli | 1.95 | 15.62 |
| Klebsiella pneumoniae | 4.10 | 31.25 |
| Candida albicans | 15.62 | 31.25 |
| Aspergillus niger | - | - |
| Concentration µg/mL | Extract | Chitosan Nanoparticles Loaded Extract | ||||
|---|---|---|---|---|---|---|
| Mean OD | Viability % | Toxicity % | Mean OD | Viability % | Toxicity % | |
| 0 | 0.786 ± 0.006 | 100.0 | 0.00 | 0.786 ± 0.006 | 100.0 | 0.00 |
| 31.25 | 0.784 ± 0.003 | 99.75 | 0.25 | 0.738 ± 0.003 | 93.89 | 6.11 |
| 62.5 | 0.777 ± 0.009 | 98.85 | 1.15 | 0.358 ± 0.004 | 45.63 | 54.37 |
| 125 | 0.558 ± 0.005 | 71.03 | 28.97 | 0.019 ± 0.032 | 13.10 | 86.90 |
| 250 | 0.131 ± 0.005 | 16.80 | 83.29 | 0.774 ± 0.788 | 7.55 | 92.45 |
| 500 | 0.019 ± 0.000 | 2.42 | 97.58 | 0.031 ± 0.002 | 3.94 | 96.06 |
| 1000 | 0.018 ± 0.001 | 2.25 | 97.75 | 0.024 ± 0.003 | 3.10 | 96.90 |
| IC50 ± SD | 173.74 ± 2.13 µg/mL | 73.89 ± 0.8 µg/mL | ||||
| Concentration µg/mL | Extract | Chitosan Nanoparticles Loaded Extract | ||||
|---|---|---|---|---|---|---|
| Mean OD | Viability % | Toxicity % | Mean OD | Viability % | Toxicity % | |
| 0 | 0.856 ± 0.003 | 100.0 | 0.00 | 0.856 ± 0.003 | 100.0 | 0.00 |
| 31.25 | 0.729 ± 0.005 | 85.20 | 14.80 | 0.224 ± 0.004 | 26.21 | 73.80 |
| 62.5 | 0.428 ± 0.001 | 50.04 | 49.96 | 0.118 ± 0.006 | 13.79 | 86.21 |
| 125 | 0.182 ± 0.008 | 21.30 | 78.70 | 0.083 ± 0.008 | 9.74 | 90.26 |
| 250 | 0.058 ± 0.003 | 6.78 | 93.22 | 0.052 ± 0.003 | 6.11 | 93.89 |
| 500 | 0.020 ± 0.001 | 2.30 | 97.70 | 0.029 ± 0.001 | 3.35 | 96.65 |
| 1000 | 0.018 ± 0.001 | 2.10 | 97.90 | 0.025 ± 0.001 | 2.41 | 97.59 |
| IC50± SD | 76.09 ± 0.6 µg/mL | 20.8 ± 0.23 µg/mL | ||||
| Mol | rseq | mseq | S | rmsd_refine | E_conf | E_place | E_score1 | E_refine | E_score2 |
|---|---|---|---|---|---|---|---|---|---|
| Kaempferol | 1 | 1 | −6.61458 | 1.230687 | 4.854888 | −82.8657 | −12.7112 | −32.7628 | −6.61458 |
| Kaempferol | 1 | 1 | −6.54383 | 1.119653 | 6.537412 | −92.123 | −12.5656 | −28.8529 | −6.54383 |
| Kaempferol | 1 | 1 | −6.54332 | 1.526945 | 12.30441 | −89.1824 | −12.9152 | −27.8703 | −6.54332 |
| Kaempferol | 1 | 1 | −6.4475 | 1.046071 | 6.208238 | −85.183 | −13.053 | −30.3745 | −6.4475 |
| Kaempferol | 1 | 1 | −6.37303 | 0.916227 | 7.082326 | −80.5611 | −12.9719 | −31.4932 | −6.37303 |
| Apigenin | 1 | 2 | −6.47986 | 0.861858 | −26.2797 | −84.5134 | −12.2088 | −32.4797 | −6.47986 |
| Apigenin | 1 | 2 | −6.47244 | 2.015834 | −29.3779 | −72.5522 | −12.15 | −27.6243 | −6.47244 |
| Apigenin | 1 | 2 | −6.27735 | 0.797183 | −25.3818 | −88.9263 | −13.4198 | −30.0022 | −6.27735 |
| Apigenin | 1 | 2 | −6.17308 | 1.56109 | −25.6403 | −63.8105 | −12.9929 | −29.4521 | −6.17308 |
| Apigenin | 1 | 2 | −6.16644 | 0.588309 | −27.4292 | −88.1041 | −12.1956 | −29.6247 | −6.16644 |
| Mol | Ligand | Receptor | Interaction | Distance | E (kcal/mol) | ||||
|---|---|---|---|---|---|---|---|---|---|
| Kaempferol | O | 23 | O | MET | 745 | (A) | H-donor | 2.90 | −1.5 |
| O | 25 | SD | MET | 780 | (A) | H-donor | 3.78 | −0.9 | |
| O | 26 | OG1 | THR | 877 | (A) | H-donor | 3.00 | −0.5 | |
| 6-ring | CB | LEU | 704 | (A) | pi-H | 4.33 | −0.5 | ||
| 6-ring | CA | ASN | 705 | (A) | pi-H | 4.47 | −0.5 | ||
| 6-ring | CD1 | PHE | 764 | (A) | pi-H | 3.88 | −0.5 | ||
| Apigenin | O | 24 | O | MET | 745 | (A) | H-donor | 2.89 | −1.6 |
| O | 26 | SD | MET | 780 | (A) | H-donor | 3.78 | −1.1 | |
| O | 27 | OG1 | THR | 877 | (A) | H-donor | 3.07 | −0.5 | |
| 6-ring | CB | LEU | 704 | (A) | pi-H | 4.36 | −0.5 | ||
| 6-ring | CA | ASN | 705 | (A) | pi-H | 4.49 | −0.5 | ||
Disclaimer/Publisher’s Note: The statements, opinions and data contained in all publications are solely those of the individual author(s) and contributor(s) and not of MDPI and/or the editor(s). MDPI and/or the editor(s) disclaim responsibility for any injury to people or property resulting from any ideas, methods, instructions or products referred to in the content. |
© 2023 by the authors. Licensee MDPI, Basel, Switzerland. This article is an open access article distributed under the terms and conditions of the Creative Commons Attribution (CC BY) license (https://creativecommons.org/licenses/by/4.0/).
Share and Cite
Qanash, H.; Bazaid, A.S.; Aldarhami, A.; Alharbi, B.; Almashjary, M.N.; Hazzazi, M.S.; Felemban, H.R.; Abdelghany, T.M. Phytochemical Characterization and Efficacy of Artemisia judaica Extract Loaded Chitosan Nanoparticles as Inhibitors of Cancer Proliferation and Microbial Growth. Polymers 2023, 15, 391. https://doi.org/10.3390/polym15020391
Qanash H, Bazaid AS, Aldarhami A, Alharbi B, Almashjary MN, Hazzazi MS, Felemban HR, Abdelghany TM. Phytochemical Characterization and Efficacy of Artemisia judaica Extract Loaded Chitosan Nanoparticles as Inhibitors of Cancer Proliferation and Microbial Growth. Polymers. 2023; 15(2):391. https://doi.org/10.3390/polym15020391
Chicago/Turabian StyleQanash, Husam, Abdulrahman S. Bazaid, Abdu Aldarhami, Bandar Alharbi, Majed N. Almashjary, Mohannad S. Hazzazi, Hashim R. Felemban, and Tarek M. Abdelghany. 2023. "Phytochemical Characterization and Efficacy of Artemisia judaica Extract Loaded Chitosan Nanoparticles as Inhibitors of Cancer Proliferation and Microbial Growth" Polymers 15, no. 2: 391. https://doi.org/10.3390/polym15020391
APA StyleQanash, H., Bazaid, A. S., Aldarhami, A., Alharbi, B., Almashjary, M. N., Hazzazi, M. S., Felemban, H. R., & Abdelghany, T. M. (2023). Phytochemical Characterization and Efficacy of Artemisia judaica Extract Loaded Chitosan Nanoparticles as Inhibitors of Cancer Proliferation and Microbial Growth. Polymers, 15(2), 391. https://doi.org/10.3390/polym15020391

